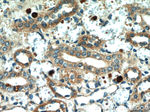
BCS1L Antibody in Immunohistochemistry (Paraffin) (IHC (P))

Search
Proteintech
BCS1L Monoclonal Antibody (3G6H1)
{{$productOrderCtrl.translations['antibody.pdp.commerceCard.promotion.promotions']}}
{{$productOrderCtrl.translations['antibody.pdp.commerceCard.promotion.viewpromo']}}
{{$productOrderCtrl.translations['antibody.pdp.commerceCard.promotion.promocode']}}: {{promo.promoCode}} {{promo.promoTitle}} {{promo.promoDescription}}. {{$productOrderCtrl.translations['antibody.pdp.commerceCard.promotion.learnmore']}}
产品信息
60212-1-IG
种属反应
宿主/亚型
分类
类型
克隆号
抗原
偶联物
形式
浓度
规格
纯化类型
保存液
内含物
保存条件
运输条件
产品详细信息
Immunogen sequence: ILALKDNPY FGAGFGLVGV GTALALARKG VQLGLVAFRR HYMITLEVPA RDRSYAWLLS WLTRHSTRTQ HLSVETSYLQ HESGRISTKF EFVPSPGNHF IWYRGKWIRV ERSREMQMID LQTGTPWESV TFTALGTDRK VFFNILEEAR ELALQQEEGK TVMYTAVGSE WRPFGYP (7-182 aa encoded by BC007500)
靶标信息
This gene encodes a homolog of the S. cerevisiae bcs1 protein which is involved in the assembly of complex III of the mitochondrial respiratory chain. The encoded protein does not contain a mitochondrial targeting sequence but experimental studies confirm that it is imported into mitochondria. Mutations in this gene are associated with mitochondrial complex III deficiency and the GRACILE syndrome. Five alternatively spliced transcripts encoding the same protein have been described.
仅用于科研。不用于诊断过程。未经明确授权不得转售。
篇参考文献 (0)
生物信息学
蛋白别名: BC1 (ubiquinol-cytochrome c reductase) synthesis-like; BCS1-like (S. cerevisiae) isoform BCS1L_1; BCS1-like (S. cerevisiae) isoform BCS1L_2; BCS1-like protein; h-BCS1; Mitochondrial chaperone BCS1; mitochondrial complex III assembly; mitochondrial protein; unnamed protein product
基因别名: 9130022O19Rik; BCS; BCS1; BCS1L; BJS; FLNMS; GRACILE; h-BCS; h-BCS1; Hs.6719; MC3DN1; PTD
UniProt ID: (Human) Q9Y276, (Mouse) Q9CZP5
Entrez Gene ID: (Human) 617, (Mouse) 66821